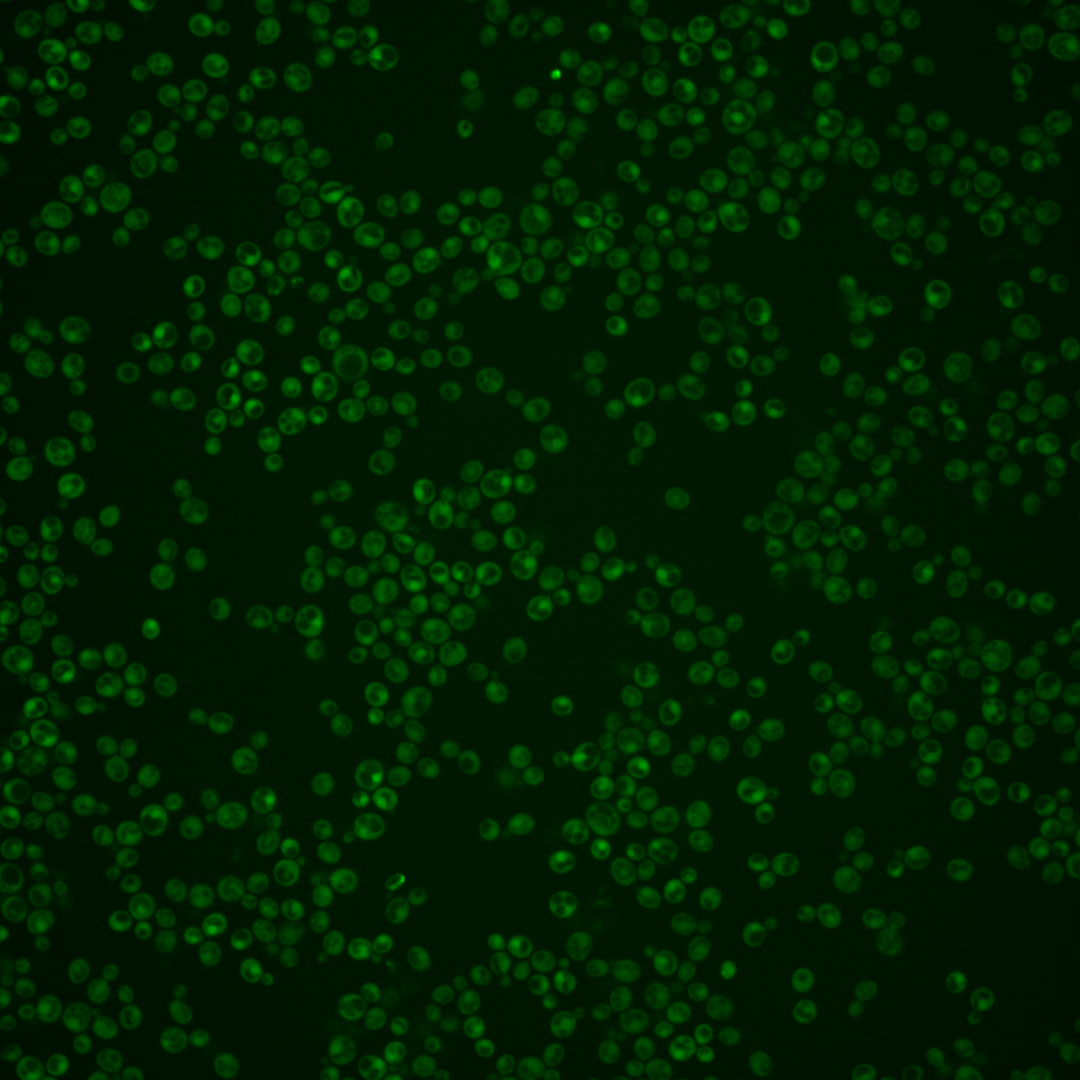

| Standard name | |
|---|---|
| Human Ortholog | |
| Description | Xanthine-guanine phosphoribosyl transferase; required for xanthine utilization and for optimal utilization of guanine |
Micrographs




















































































Sub-cellular Localization
Yeast GFP Assignment
Protein Abundance
Localization Change
External localization resources
| ensLOC | DeepLoc | |||||||||||||||||||||||
|---|---|---|---|---|---|---|---|---|---|---|---|---|---|---|---|---|---|---|---|---|---|---|---|---|
| Localization | WT1 | WT2 | WT3 | RAP60 | RAP140 | RAP220 | RAP300 | RAP380 | RAP460 | RAP540 | RAP620 | RAP700 | HU80 | HU120 | HU160 | rpd3Δ_1 | rpd3Δ_2 | rpd3Δ_3 | WT1 | WT2 | WT3 | AF100 | AF140 | AF180 |
| Cortical Patches | 0 | 0 | 1 | 0 | 1 | 0 | 0 | – | 0 | 0 | 0 | 0 | 0 | 0 | 0 | 0 | 0 | 0 | 1 | 0 | 0 | 0 | 4 | 4 |
| Bud | 0 | 1 | 1 | 1 | 0 | 2 | 0 | – | 0 | 1 | 1 | 5 | 0 | 0 | 0 | 0 | 0 | 0 | 4 | 0 | 1 | 2 | 10 | 9 |
| Bud Neck | 0 | 0 | 1 | 0 | 0 | 0 | 0 | – | 0 | 0 | 0 | 0 | 0 | 0 | 0 | 0 | 0 | 0 | 0 | 0 | 0 | 0 | 1 | 2 |
| Bud Site | 0 | 0 | 0 | 0 | 0 | 0 | 0 | – | 0 | 0 | 0 | 0 | 0 | 0 | 0 | 0 | 0 | 0 | – | – | – | – | – | – |
| Cell Periphery | 1 | 0 | 0 | 1 | 0 | 0 | 2 | – | 1 | 3 | 4 | 16 | 1 | 0 | 2 | 4 | 8 | 6 | 0 | 0 | 0 | 0 | 0 | 1 |
| Cytoplasm | 253 | 89 | 17 | 60 | 148 | 69 | 188 | – | 59 | 115 | 108 | 147 | 237 | 413 | 408 | 366 | 228 | 297 | 235 | 80 | 46 | 195 | 375 | 339 |
| Endoplasmic Reticulum | 0 | 0 | 0 | 0 | 1 | 0 | 8 | – | 3 | 3 | 1 | 0 | 0 | 1 | 0 | 8 | 6 | 5 | 1 | 1 | 0 | 0 | 2 | 6 |
| Endosome | 2 | 0 | 0 | 0 | 1 | 0 | 0 | – | 0 | 0 | 1 | 1 | 0 | 2 | 2 | 1 | 1 | 2 | 0 | 1 | 0 | 0 | 4 | 13 |
| Golgi | 0 | 0 | 0 | 0 | 1 | 0 | 0 | – | 0 | 0 | 0 | 0 | 0 | 0 | 0 | 2 | 1 | 0 | 1 | 0 | 0 | 0 | 3 | 3 |
| Mitochondria | 0 | 4 | 0 | 0 | 0 | 8 | 7 | – | 13 | 23 | 34 | 48 | 0 | 0 | 0 | 0 | 1 | 3 | 1 | 4 | 0 | 1 | 9 | 14 |
| Nucleus | 2 | 1 | 0 | 0 | 2 | 1 | 8 | – | 4 | 3 | 9 | 14 | 2 | 1 | 1 | 7 | 4 | 3 | 0 | 0 | 0 | 0 | 0 | 2 |
| Nuclear Periphery | 0 | 1 | 0 | 0 | 1 | 0 | 0 | – | 0 | 1 | 0 | 0 | 0 | 0 | 0 | 0 | 0 | 0 | 0 | 0 | 0 | 0 | 0 | 1 |
| Nucleolus | 0 | 0 | 0 | 0 | 0 | 0 | 0 | – | 0 | 0 | 0 | 0 | 1 | 0 | 0 | 0 | 1 | 3 | 0 | 0 | 0 | 1 | 0 | 0 |
| Peroxisomes | 0 | 0 | 0 | 0 | 0 | 0 | 0 | – | 0 | 0 | 0 | 0 | 0 | 0 | 0 | 0 | 0 | 0 | 0 | 0 | 0 | 0 | 0 | 0 |
| SpindlePole | 1 | 0 | 0 | 0 | 0 | 0 | 0 | – | 0 | 0 | 0 | 0 | 1 | 0 | 0 | 0 | 0 | 1 | 2 | 0 | 0 | 0 | 9 | 8 |
| Vac/Vac Membrane | 3 | 0 | 0 | 3 | 33 | 10 | 43 | – | 20 | 37 | 26 | 51 | 2 | 4 | 12 | 22 | 17 | 20 | 0 | 1 | 0 | 1 | 1 | 4 |
| Unique Cell Count | 259 | 92 | 17 | 62 | 174 | 84 | 239 | 93 | 167 | 164 | 242 | 241 | 419 | 416 | 386 | 241 | 314 | 252 | 93 | 49 | 207 | 431 | 418 | |
| Labelled Cell Count | 262 | 96 | 20 | 65 | 188 | 90 | 256 | 100 | 186 | 184 | 282 | 244 | 421 | 425 | 410 | 267 | 340 | 252 | 93 | 49 | 207 | 431 | 418 | |
Yeast GFP Assignment
Protein Abundance
| Screen | WT1 | WT2 | WT3 | RAP60 | RAP140 | RAP220 | RAP300 | RAP380 | RAP460 | RAP540 | RAP620 | RAP700 | HU80 | HU120 | HU160 | rpd3Δ_1 | rpd3Δ_2 | rpd3Δ_3 | AF100 | AF140 | AF180 |
|---|---|---|---|---|---|---|---|---|---|---|---|---|---|---|---|---|---|---|---|---|---|
| Mean Cell GFP Intensity (1e-4) | 5.6 | 5.1 | 6.3 | 7.1 | 10.5 | 6.8 | 9.8 | – | 8.2 | 8.2 | 7.7 | 8.4 | 7.2 | 6.8 | 6.5 | 10.9 | 11.3 | 11.1 | 6.1 | 6.2 | 6.3 |
| Std Deviation (1e-4) | 2.0 | 1.6 | 1.3 | 2.0 | 2.2 | 1.6 | 2.5 | – | 1.8 | 2.1 | 2.0 | 2.0 | 2.2 | 1.8 | 1.7 | 2.3 | 2.2 | 2.2 | 2.0 | 2.2 | 2.5 |
| Intensity Change (Log2) | – | – | – | 0.18 | 0.74 | 0.13 | 0.65 | – | 0.39 | 0.4 | 0.3 | 0.42 | 0.2 | 0.13 | 0.05 | 0.8 | 0.85 | 0.83 | -0.04 | -0.01 | 0.01 |
Localization Change
| Localization | RAP60 | RAP140 | RAP220 | RAP300 | RAP380 | RAP460 | RAP540 | RAP620 | RAP700 | HU80 | HU120 | HU160 | rpd3Δ_1 | rpd3Δ_2 | rpd3Δ_3 |
|---|---|---|---|---|---|---|---|---|---|---|---|---|---|---|---|
| Cortical Patches | 0 | 0 | 0 | 0 | – | 0 | 0 | 0 | 0 | 0 | 0 | 0 | 0 | 0 | 0 |
| Bud | 0 | 0 | 0 | 0 | – | 0 | 0 | 0 | 0 | 0 | 0 | 0 | 0 | 0 | 0 |
| Bud Neck | 0 | 0 | 0 | 0 | – | 0 | 0 | 0 | 0 | 0 | 0 | 0 | 0 | 0 | 0 |
| Bud Site | 0 | 0 | 0 | 0 | – | 0 | 0 | 0 | 0 | 0 | 0 | 0 | 0 | 0 | 0 |
| Cell Periphery | 0 | 0 | 0 | 0 | – | 0 | 0 | 0 | 0 | 0 | 0 | 0 | 0 | 0 | 0 |
| Cytoplasm | -0.8 | -1.7 | -1.9 | -2.1 | – | -3.0 | -2.7 | -2.9 | -3.2 | -0.5 | -0.5 | -0.6 | -1.0 | -1.0 | -1.0 |
| Endoplasmic Reticulum | 0 | 0 | 0 | 0 | – | 0 | 0 | 0 | 0 | 0 | 0 | 0 | 0 | 0 | 0 |
| Endosome | 0 | 0 | 0 | 0 | – | 0 | 0 | 0 | 0 | 0 | 0 | 0 | 0 | 0 | 0 |
| Golgi | 0 | 0 | 0 | 0 | – | 0 | 0 | 0 | 0 | 0 | 0 | 0 | 0 | 0 | 0 |
| Mitochondria | 0 | 0 | 0 | 0 | – | 0 | 0 | 0 | 0 | 0 | 0 | 0 | 0 | 0 | 0 |
| Nucleus | 0 | 0 | 0 | 0 | – | 0 | 0 | 0 | 0 | 0 | 0 | 0 | 0 | 0 | 0 |
| Nuclear Periphery | 0 | 0 | 0 | 0 | – | 0 | 0 | 0 | 0 | 0 | 0 | 0 | 0 | 0 | 0 |
| Nucleolus | 0 | 0 | 0 | 0 | – | 0 | 0 | 0 | 0 | 0 | 0 | 0 | 0 | 0 | 0 |
| Peroxisomes | 0 | 0 | 0 | 0 | – | 0 | 0 | 0 | 0 | 0 | 0 | 0 | 0 | 0 | 0 |
| SpindlePole | 0 | 0 | 0 | 0 | – | 0 | 0 | 0 | 0 | 0 | 0 | 0 | 0 | 0 | 0 |
| Vacuole | 0 | 0 | 0 | 0 | – | 0 | 0 | 0 | 0 | 0 | 0 | 0 | 0 | 0 | 0 |
External localization resources
Images






























Protein Concentration and Protein Localization Data
| R1 | R2 | R3 | ||||||||||||||||
|---|---|---|---|---|---|---|---|---|---|---|---|---|---|---|---|---|---|---|
| G1 Pre-START | G1 Post-START | S/G2 | Metaphase | Anaphase | Telophase | G1 Pre-START | G1 Post-START | S/G2 | Metaphase | Anaphase | Telophase | G1 Pre-START | G1 Post-START | S/G2 | Metaphase | Anaphase | Telophase | |
| Concentration | -0.4483 | 0.2066 | -0.3217 | -0.1954 | -0.5642 | -0.3929 | 0.3853 | 1.1545 | 0.9471 | 0.3037 | 0.786 | 1.0025 | 1.6406 | 2.6839 | 2.0266 | 2.7627 | 1.7072 | 2.4891 |
| Actin | 0.03 | 0.0004 | 0.0053 | 0.0165 | 0.0171 | 0.003 | 0.0089 | 0.0002 | 0.005 | 0.0331 | 0.031 | 0.0045 | 0.0018 | 0.0002 | 0.0004 | 0.0112 | 0.0122 | 0.0002 |
| Bud | 0.001 | 0.0003 | 0.0009 | 0.0004 | 0.0013 | 0.0021 | 0.0009 | 0.0003 | 0.0017 | 0.0003 | 0.0021 | 0.0002 | 0 | 0.0002 | 0.0004 | 0.0005 | 0.0002 | 0 |
| Bud Neck | 0.0024 | 0.0002 | 0.0025 | 0.0014 | 0.001 | 0.0053 | 0.003 | 0.0003 | 0.0005 | 0.0005 | 0.0012 | 0.0019 | 0.0005 | 0.0001 | 0.0001 | 0.0002 | 0.0002 | 0.0002 |
| Bud Periphery | 0.0016 | 0.0003 | 0.0006 | 0.0008 | 0.0034 | 0.0006 | 0.0012 | 0.0002 | 0.0014 | 0.0003 | 0.0025 | 0.0002 | 0 | 0.0002 | 0.0008 | 0.0006 | 0.0005 | 0 |
| Bud Site | 0.0051 | 0.0018 | 0.0013 | 0.0011 | 0.0037 | 0.0004 | 0.0095 | 0.0102 | 0.0024 | 0.0006 | 0.0009 | 0.0001 | 0.0001 | 0.0026 | 0.0004 | 0.0005 | 0.0001 | 0 |
| Cell Periphery | 0.0004 | 0.0001 | 0.0001 | 0.0001 | 0.0003 | 0.0001 | 0.0004 | 0.0002 | 0.0001 | 0.0001 | 0.0001 | 0 | 0.0001 | 0.0001 | 0.0001 | 0.0001 | 0.0001 | 0 |
| Cytoplasm | 0.3894 | 0.6148 | 0.4562 | 0.4966 | 0.4562 | 0.5119 | 0.4166 | 0.5781 | 0.495 | 0.4587 | 0.567 | 0.6148 | 0.1779 | 0.3591 | 0.319 | 0.2662 | 0.3257 | 0.382 |
| Cytoplasmic Foci | 0.0455 | 0.0097 | 0.0188 | 0.0231 | 0.0166 | 0.0228 | 0.0268 | 0.0056 | 0.0123 | 0.0102 | 0.0224 | 0.0114 | 0.0026 | 0.0054 | 0.0047 | 0.0117 | 0.0069 | 0.0039 |
| Eisosomes | 0.0004 | 0 | 0.0001 | 0.0002 | 0.0007 | 0.0001 | 0.0004 | 0.0001 | 0.0001 | 0.0002 | 0.0001 | 0.0001 | 0.0004 | 0 | 0.0001 | 0.0001 | 0.0002 | 0 |
| Endoplasmic Reticulum | 0.0055 | 0.0031 | 0.0027 | 0.0052 | 0.0035 | 0.0021 | 0.0044 | 0.0018 | 0.0028 | 0.002 | 0.0027 | 0.0014 | 0.0022 | 0.0012 | 0.0015 | 0.0014 | 0.0013 | 0.0016 |
| Endosome | 0.0284 | 0.0043 | 0.0109 | 0.0225 | 0.02 | 0.0077 | 0.0201 | 0.0018 | 0.0119 | 0.0064 | 0.0255 | 0.0032 | 0.0013 | 0.0026 | 0.0008 | 0.0035 | 0.0018 | 0.0014 |
| Golgi | 0.0059 | 0.0002 | 0.0029 | 0.0087 | 0.0142 | 0.001 | 0.0038 | 0.0001 | 0.003 | 0.0047 | 0.01 | 0.0008 | 0.0003 | 0.0002 | 0.0001 | 0.0006 | 0.0003 | 0.0001 |
| Lipid Particles | 0.0097 | 0.0002 | 0.0031 | 0.0289 | 0.0099 | 0.0016 | 0.0099 | 0.0002 | 0.004 | 0.006 | 0.0103 | 0.0025 | 0.0003 | 0.0003 | 0.0001 | 0.0008 | 0.0001 | 0.0001 |
| Mitochondria | 0.0135 | 0.0004 | 0.0063 | 0.0052 | 0.0089 | 0.0007 | 0.0114 | 0.0001 | 0.0022 | 0.0027 | 0.0019 | 0.0004 | 0.0001 | 0.0001 | 0.0002 | 0.0005 | 0.0003 | 0.0001 |
| None | 0.4169 | 0.3546 | 0.4769 | 0.3339 | 0.3957 | 0.4217 | 0.4521 | 0.3951 | 0.4341 | 0.4561 | 0.3018 | 0.3432 | 0.8081 | 0.625 | 0.6679 | 0.6906 | 0.6467 | 0.607 |
| Nuclear Periphery | 0.0116 | 0.0014 | 0.0019 | 0.0057 | 0.0192 | 0.0022 | 0.006 | 0.0007 | 0.0072 | 0.0019 | 0.0026 | 0.0026 | 0.0018 | 0.0005 | 0.0005 | 0.0015 | 0.0005 | 0.0005 |
| Nucleolus | 0.0013 | 0.0003 | 0.0003 | 0.0013 | 0.0026 | 0.0003 | 0.0015 | 0.0001 | 0.0003 | 0.0001 | 0.0002 | 0.0003 | 0.0002 | 0.0001 | 0.0001 | 0.0002 | 0.0001 | 0 |
| Nucleus | 0.005 | 0.0036 | 0.0029 | 0.0045 | 0.0048 | 0.0072 | 0.0062 | 0.0025 | 0.0054 | 0.0102 | 0.0036 | 0.0054 | 0.0009 | 0.0008 | 0.0012 | 0.0016 | 0.0012 | 0.0017 |
| Peroxisomes | 0.0084 | 0.0002 | 0.0012 | 0.0345 | 0.0027 | 0.0011 | 0.0055 | 0.0001 | 0.0061 | 0.0021 | 0.0059 | 0.0025 | 0.0001 | 0.0001 | 0.0003 | 0.0023 | 0.0004 | 0.0001 |
| Punctate Nuclear | 0.0122 | 0.0013 | 0.0026 | 0.006 | 0.0093 | 0.0071 | 0.008 | 0.0009 | 0.0021 | 0.0024 | 0.0052 | 0.0034 | 0.0008 | 0.0006 | 0.0008 | 0.0038 | 0.0006 | 0.0005 |
| Vacuole | 0.0044 | 0.0025 | 0.0017 | 0.0022 | 0.0056 | 0.0009 | 0.0028 | 0.0014 | 0.0016 | 0.001 | 0.0025 | 0.0007 | 0.0003 | 0.0007 | 0.0004 | 0.0016 | 0.0004 | 0.0003 |
| Vacuole Periphery | 0.0014 | 0.0002 | 0.0006 | 0.0011 | 0.0033 | 0.0002 | 0.0008 | 0.0001 | 0.0006 | 0.0003 | 0.0008 | 0.0002 | 0.0001 | 0.0001 | 0.0001 | 0.0004 | 0.0001 | 0.0001 |
Sequencing Data
| R1 | R2 | |||||||||
|---|---|---|---|---|---|---|---|---|---|---|
| G1 Post-START | S/G2 | Metaphase | Anaphase | Telophase | G1 Post-START | S/G2 | Metaphase | Anaphase | Telophase | |
| Gene Expression | 42.0345 | 37.5762 | 45.3102 | 33.5944 | 17.0311 | 45.5121 | 38.7848 | 36.8617 | 37.3676 | 34.4526 |
| Translational Efficiency | 0.971 | 1.1194 | 0.8928 | 1.265 | 2.1093 | 0.9678 | 1.072 | 1.256 | 1.3567 | 1.4137 |
Hit Data
| Dataset | Hit |
|---|---|
| Protein Concentration | ✘ |
| Protein Localization | ✘ |
| Gene Expression | ✘ |
| Translational Efficiency | ✘ |
Endocytosis
| Temp | Actin Patch (Sac6-tdTomato) | Cortical Patch (Sla1-GFP) | Late Endosome (Snf7-GFP) | Vacuole (Vph1-GFP) |
|---|---|---|---|---|
| 37℃ | ||||
| RT |
Cell Cycle Omics
CYCLoPs (Xpt1-GFP)
| Gene / Allele | Actin Patch (Sac6-tdTomato) | Cortical Patch (Sla1-GFP) | Late Endosome (Snf7-GFP) | Vacuole (Sac6-tdTomato) |
|---|
| Gene | Images |
|---|
| Gene | Images |
|---|
Images are not yet available
Images are not yet available